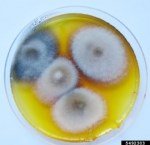
Erken Yanıklık Hastalığı Belirtileri, Nedenleri Ve Mücadele Yöntemleri

Erken Yanıklık Hastalığı Belirtileri, Nedenleri Ve Mücadele Yöntemleri
Erken Yanıklık Hastalığı
(Alternaria solani)
Bu hastalık, domates, patates, patlıcan gibi Solanaceae familyası bitkilerinde yaygın görülen, yaprak, gövde ve meyvelerde zarar oluşturan önemli bir fungal hastalıktır.
1. Belirtileri
Yapraklarda:
- Önce küçük, kahverengi, hedef tahtası (halka halka) şeklinde lekeler görülür.
- Lekeler birleşerek genişler, yapraklar sararır ve erken dökülür.
- Alt yapraklarda başlar, yukarıya doğru ilerler.
Gövde ve saplarda:
- Koyu kahverengi, bazen çökük lekeler.
- Fidelerde boğaz çürüklüğü benzeri zayıflama.
Meyvelerde:
- Kahverengi-siyah çökük lekeler, bazen halkalı yapı.
- Enfeksiyon genellikle sap ucundan başlar.
2. Gelişme Koşulları
- Hastalık etmeni toprakta, bitki artıklarında ve tohum üzerinde spor halinde kışlar.
- Yüksek nem (%85+) ve 20–30 °C sıcaklık hastalığı hızlandırır.
- Yağmur, sulama suyu ve rüzgâr ile yayılır.
3. Mücadele Yöntemleri
Kültürel Önlemler
- En az 2–3 yıl ürün rotasyonu yapılmalı (özellikle Solanaceae dışı bitkiler ekilmeli).
- Hastalıklı bitki artıkları toplanıp imha edilmeli.
- Damla sulama tercih edilmeli, yaprak ıslatılmamalı.
- Sık dikimden kaçınılmalı, hava sirkülasyonu sağlanmalı.
- Dayanıklı çeşitler tercih edilmeli.
Kimyasal Mücadele
İlk ilaçlama: İlk yaprak lekeleri görülür görülmez.
Tekrar ilaçlama: Hastalık ve iklim durumuna göre 7–10 gün arayla.
Etkili etken maddeler (örnek):
- Mancozeb
- Klorotalonil
- Azoksistrobin
- Difenokonazol
- Tebuconazole
- Bakırlı preparatlar (özellikle organik üretimde)
💡 İlaç değişimi yapılmalı, aynı etken madde üst üste kullanılmamalı (fungus direnç geliştirebilir).
4. Önleme Stratejisi
- Ekim öncesi tohum ilaçlaması yapılmalı.
- Hasat sonrası tarla temizlenmeli, derin sürüm yapılmalı.
- Bitki stresini azaltmak için dengeli gübreleme (fazla azot hastalığı artırır) uygulanmalı.
1. Domates – Erken Yanıklık Hastalığı Takvimi
| Ay | Yapılacak İşlemler | Açıklama |
|---|---|---|
| Şubat – Mart | Tohum seçimi ve ilaçlama | Sertifikalı ve hastalıksız tohum kullan, gerekiyorsa tohum ilaçlaması yap. |
| Nisan | Fide dönemi kontrolü | Fide yapraklarında ilk lekeler görülürse koruyucu fungisit (Mancozeb, Klorotalonil) uygula. |
| Mayıs | Dikim ve kültürel önlem | Sık dikimden kaçın, damla sulama kullan, alt yaprakları yerden 20–30 cm yükseklikte bırak. |
| Haziran | İlk ilaçlama | Alt yapraklarda halka şeklinde lekeler görülür görülmez ilaçlama başla. 7–10 günde bir tekrarla. |
| Temmuz | Düzenli ilaçlama | Mancozeb, Azoksistrobin veya Difenokonazol dönüşümlü kullan. İlaç değişimini unutma. |
| Ağustos | Yaprak temizliği | Aşırı hastalıklı yaprakları buda, tarladan uzaklaştır. İlaçlamaya devam et. |
| Eylül | Hasat sonrası temizlik | Bitki artıkları tarladan çıkar, derin sürüm yap. |
2. Patates – Erken Yanıklık Hastalığı Takvimi
| Ay | Yapılacak İşlemler | Açıklama |
|---|---|---|
| Ocak – Şubat | Tohumluk seçimi | Sertifikalı, sağlıklı patates tohumu kullan. |
| Mart | Ekim öncesi tohum ilaçlama | Fungisit ile (Mancozeb vb.) kaplama yap. |
| Nisan – Mayıs | Bitki çıkışı ve ilk kontrol | İlk yaprak lekelerinde ilaçlama başla. |
| Haziran | Düzenli ilaçlama | Klorotalonil, Azoksistrobin, Tebuconazole dönüşümlü kullan. 7–10 günde bir. |
| Temmuz | Kültürel önlem | Alt yaprak temizliği, dengeli gübreleme (azot fazlasından kaçın). |
| Ağustos | Hastalık takibi | İklim nemliyse ilaçlama aralıklarını kısalt (5–7 gün). |
| Eylül | Hasat sonrası temizlik | Bitki artıkları uzaklaştır, derin sürüm yap, tarlayı boş bırakma (rotasyon). |
💡 Ek ipuçları:
- Aynı etken maddeyi 2’den fazla üst üste kullanma.
- Sulamayı sabah yap, yaprakların gece ıslak kalmamasını sağla.
- Domates ve patates aynı aileden olduğundan hastalık kolay bulaşır, aynı yıl aynı tarlada yetiştirme.
İlginizi Çekebilecek Konu Başlıkları
BU KONU HAKKINDAKİ YORUMUNUZ NEDİR?